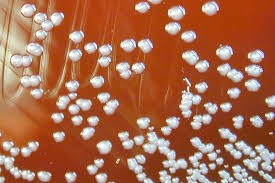
bacteria

Rare and Emerging Pathogens: Unusual Isolates from Clinical Cultures Highlight Diagnostic and Treatment Challenges
1) Very rare Bacteria “Burkholderia pseumallei “isolated from Brain abscess.
Burkholderia pseudomallei (also known as Pseudomonas pseudomallei) is a Gram-negative, bipolar, aerobic, motile rod-shaped bacterium It is a soil-dwelling bacterium endemic in tropical and subtropical regions worldwide, particularly in Thailand and northern Australia.
Burkholderia pseudomallei infection in humans is called melioidosis or Whitmore's disease. It is spread through direct contact with water or soil that holds the bacteria. There have been few cases of transmission of the bacteria perinatally. Its mortality is 20 to 50% even with treatment.
2) Rare Bacteria “Pasturella canis” isolated from Blood culture .
Pasteurella canis is a Gram-negative, nonmotile, penicillin-sensitive coccobacillus of the family Pasteurellaceae. Bacteria from this family cause zoonotic infections in humans, which manifest themselves as skin or soft-tissue infections after an animal bite. It has been known to cause serious disease in immunocompromised patients.
P. canis usually does not affect humans, but may be transmitted from animals to humans through animal bites, scratches, or licking over wounds. However, some patients developed infections without any scratches and puncture wounds. In one case, a patient exposed to rabbit secretions was infected with P. canis. Those with rheumatoid arthritis, cirrhosis, and diabetes mellitus are more susceptible to the bacteria. Patients who are immunocompromised also have higher risk of infections.

3) RARE FUNGUS ISOLATED FROM SPUTUM CULTURE: Saprochaete Capitata
Saprochaete capita is a saprophytic soil yeast and may rarely cause invasive systemic infections in immunocompromised patients. Saprochaete capitata infection represents a life-threatening mycosis in severely immunocompromised patients. The successful outcome of treatment seems to be critically dependent on the early diagnosis and the recovery of underlying conditions associated with immune dysfunction or deficiency. Saprochaete spp. are found resistant to commonly used antifungals echinocandins and fluconazole, so the treatment is often difficult.

Speak with our Contact Center for assistance


